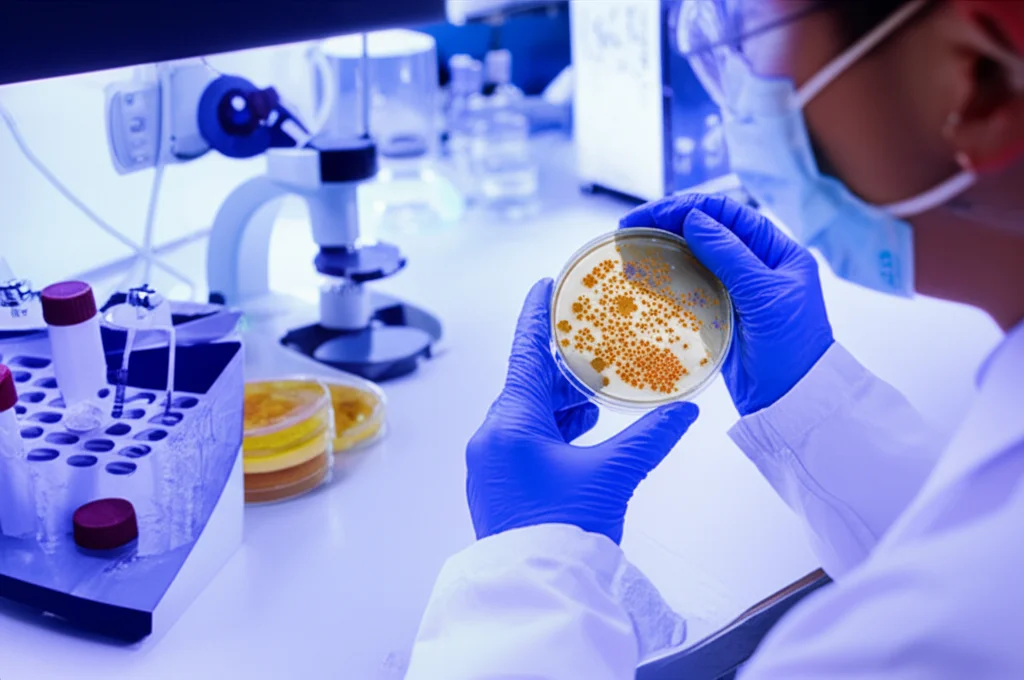
Immagine realistica di un tecnico di laboratorio che esamina delle piastre Petri con colonie batteriche sotto una luce da banco. Focus sulle piastre con diverse densità di colonie. Obiettivo macro 60mm, high detail, precise focusing, controlled lighting.

Frigo Solare Mobile su Ruote: La Rivoluzione Contro lo Spreco Alimentare nel Trasporto Agricolo
Ciao a tutti! Oggi voglio parlarvi di qualcosa che mi sta davvero a cuore e che, credetemi, riguarda tutti noi: lo spreco alimentare. Pensateci un attimo: tonnellate di cibo, specialmente frutta e verdura freschissime, che vanno perse prima ancora di arrivare sulle nostre tavole. Un problema enorme, non solo per le nostre tasche, ma anche per la sicurezza alimentare globale e per l’ambiente.
In India, un paese dove l’agricoltura è un pilastro fondamentale dell’economia (parliamo del 18% del PIL!), questo problema è particolarmente sentito. Immaginate: sono secondi al mondo per produzione ortofrutticola, ma una fetta enorme di questa ricchezza, tra il 6% e il 15% della frutta, si perde dopo il raccolto. La causa principale? La mancanza di una catena del freddo efficiente e capillare, soprattutto nelle zone rurali. Mantenere frutta e verdura alla giusta temperatura e umidità è cruciale per rallentare il deterioramento e la crescita di batteri e muffe. Senza questo controllo, la qualità crolla e la vita utile dei prodotti si accorcia drasticamente.
La Sfida: Un Nemico Silenzioso Chiamato “Perdita Post-Raccolta”
La fame e la malnutrizione sono ancora piaghe globali. Secondo il World Food Programme, quasi 828 milioni di persone rischiano la fame, e le cause sono molteplici: difficoltà nella gestione del cibo, cambiamenti climatici che devastano i raccolti, instabilità economica e politica. La pandemia di Covid-19 ha peggiorato ulteriormente la situazione, raddoppiando quasi il numero di persone che soffrono la fame acuta.
E qui entra in gioco lo spreco. L’ONU stima che circa il 13,3% del cibo mondiale si perda dopo il raccolto, prima ancora di raggiungere i negozi. Se aggiungiamo lo spreco a livello di consumatori (un altro 17%), capite bene l’entità del disastro. La FAO parla di circa un terzo di tutto il cibo prodotto per il consumo umano che finisce sprecato ogni anno! Questo non è solo uno spreco di cibo, ma anche di risorse preziose come acqua (pensate a 250 km³ di acqua dolce sprecata, l’equivalente del fiume Volga!) e terra (1,4 miliardi di ettari, il 30% dei terreni agricoli mondiali!). Inoltre, il cibo sprecato contribuisce pesantemente alle emissioni di gas serra (GHG), rappresentando l’8-10% delle emissioni globali. Se lo spreco alimentare fosse un paese, sarebbe il terzo più grande emettitore di GHG dopo USA e Cina!
In India, le perdite post-raccolta ammontano a cifre da capogiro (circa 92.651 crore di INR all’anno, secondo stime) e contribuiscono al 6-10% delle emissioni totali di GHG del paese. La mancanza di infrastrutture di refrigerazione decentralizzate e di un trasporto efficiente, specialmente per l'”ultimo miglio” dalle campagne ai mercati, aggrava il problema.

La Nostra Idea: Un Frigo Mobile Alimentato dal Sole!
Di fronte a questa sfida, ci siamo chiesti: come possiamo intervenire in modo concreto, sostenibile ed efficace? Ed ecco l’idea: un sistema di micro-refrigerazione mobile (MCS – Micro Cold Storage), alimentato interamente da energia solare fotovoltaica e progettato per essere integrato facilmente con i veicoli elettrici (EV). Geniale, vero?
Immaginate un piccolo box refrigerato, con una capacità di circa 12 litri, che utilizza una tecnologia chiamata raffreddamento termoelettrico (TEC). Niente compressori rumorosi o gas refrigeranti dannosi per l’ambiente. I moduli TEC sono dispositivi a stato solido, compatti, affidabili, a bassa manutenzione e perfetti per il controllo preciso della temperatura. Il tutto alimentato da un pannello solare da 100 Wp, un regolatore di carica e una batteria da 12V/40Ah per garantire il funzionamento anche quando il sole non splende. Un sistema completamente off-grid, pulito e rinnovabile!
Il bello è che questo MCS può essere montato su un veicolo elettrico, come un risciò o un piccolo furgone. Questo permette di creare una vera e propria catena del freddo mobile, perfetta per coprire quell’ultimo, cruciale miglio che separa i campi agricoli dai mercati o dai centri di raccolta, specialmente nelle aree rurali dove le infrastrutture fisse scarseggiano.
Mettiamolo alla Prova: Uva Fresca Sotto Esame
Per vedere se la nostra idea funzionava davvero, abbiamo condotto una serie di esperimenti. Abbiamo scelto l’uva (Vitis vinifera), un frutto delizioso ma notoriamente delicato e con una breve vita post-raccolta, che richiede temperature basse per non deteriorarsi.
Abbiamo preso grappoli di uva fresca, appena raccolta, e li abbiamo divisi in due gruppi:
- Un gruppo conservato nel nostro MCS, mantenuto a una temperatura controllata tra +2°C e +8°C.
- Un gruppo di controllo conservato a temperatura ambiente.
Abbiamo monitorato tutto per una settimana, misurando principalmente la perdita fisiologica di peso (PLW), un indicatore chiave della freschezza e della disidratazione. Ma non ci siamo fermati qui!
Abbiamo anche simulato il trasporto su breve distanza (6 ore), integrando l’MCS con un risciò elettrico alimentato a energia solare, per vedere come si comportava “in movimento”. E, cosa fondamentale, abbiamo analizzato la carica microbica (batteri, lieviti e funghi) sull’uva prima e dopo la conservazione, sia a breve che a lungo termine, utilizzando la tecnica della conta delle unità formanti colonia (CFU/ml). Volevamo essere sicuri che il nostro sistema non solo mantenesse l’uva bella da vedere, ma anche sicura da mangiare!
I Risultati? Sorprendenti!
Ebbene, i risultati sono stati davvero incoraggianti!
L’uva conservata nel nostro MCS ha mostrato una riduzione della perdita di peso controllata fino all’87,6% rispetto a quella lasciata a temperatura ambiente. In pratica, è rimasta molto più fresca e idratata! Le foto parlano chiaro: dopo una settimana, l’uva a temperatura ambiente era avvizzita e rovinata, mentre quella nel nostro frigo solare era ancora turgida e invitante.
Dal punto di vista termico ed elettrico, il sistema si è comportato egregiamente. Raggiungeva la temperatura desiderata (+2°C a +8°C) in circa 30-60 minuti e la manteneva stabile, sia in condizioni statiche che dinamiche (durante il trasporto sul risciò elettrico). Anzi, abbiamo notato che il movimento del veicolo aiutava persino a dissipare meglio il calore dal lato caldo del modulo TEC, migliorando leggermente l’efficienza! Il sistema consumava circa 50-55W, un carico gestibile per un piccolo impianto solare e una batteria tampone. Il Coefficiente di Performance (COP), che misura l’efficienza di un sistema di refrigerazione, variava tra 0.03 e 0.7, valori tipici per i TEC ma sufficienti per questa applicazione specifica.
Ma la vera magia l’abbiamo vista con l’analisi microbica. La crescita di batteri, funghi e lieviti è stata drasticamente ridotta nell’uva conservata nell’MCS rispetto a quella a temperatura ambiente.
- Conservazione lunga (1 settimana): Crescita batterica ridotta del 90.86%, fungina del 90.7%, dei lieviti del 98.56%.
- Conservazione breve (6 ore): Crescita batterica ridotta dell’87%, crescita fungina e di lieviti praticamente assente.
Questo significa non solo un prodotto più bello e duraturo, ma soprattutto più sicuro per il consumo!

Perché Tutto Questo è Importante?
Questa tecnologia, amici miei, ha un potenziale enorme. Offre una soluzione concreta e sostenibile per:
- Ridurre drasticamente le perdite post-raccolta, aumentando la disponibilità di cibo fresco.
- Migliorare il reddito dei piccoli agricoltori, permettendo loro di conservare e trasportare meglio i loro prodotti, aggiungendo valore.
- Garantire la sicurezza alimentare, riducendo la contaminazione microbica.
- Promuovere la sostenibilità ambientale, utilizzando energia solare pulita e riducendo le emissioni di GHG associate sia allo spreco alimentare che ai sistemi di refrigerazione tradizionali (stimiamo un risparmio potenziale di 692-700 kg di CO2 all’anno per unità rispetto a un sistema a compressione di vapore).
- Colmare il divario dell'”ultimo miglio” nella catena del freddo, specialmente nelle aree rurali e remote.
- Contribuire agli Obiettivi di Sviluppo Sostenibile (SDG) dell’ONU, in particolare SDG 7 (Energia Pulita e Accessibile) e SDG 12 (Consumo e Produzione Responsabili).
Uno Sguardo al Futuro
Certo, ci sono ancora sfide da affrontare e margini di miglioramento. Dobbiamo ottimizzare i tempi per raggiungere la temperatura desiderata, perfezionare i sistemi di gestione della batteria per l’integrazione con gli EV, magari studiare materiali termoelettrici ancora più efficienti. Sarà importante testare il sistema con altri tipi di frutta e verdura, valutare l’integrazione con altre fonti rinnovabili o trattamenti post-raccolta (come acqua calda o UV), e magari aggiungere sensori IoT per il monitoraggio remoto.
Fondamentale sarà anche valutare la fattibilità economica e la scalabilità di questa soluzione per renderla accessibile ai piccoli agricoltori. Ma la strada è tracciata!
Credo fermamente che l’integrazione tra energia rinnovabile, tecnologie di refrigerazione innovative e mobilità elettrica possa davvero rivoluzionare la filiera agroalimentare, rendendola più resiliente, sostenibile e giusta. È un piccolo passo tecnologico, ma un grande balzo verso un futuro con meno sprechi e più cibo buono e sicuro per tutti.
Fonte: Springer
